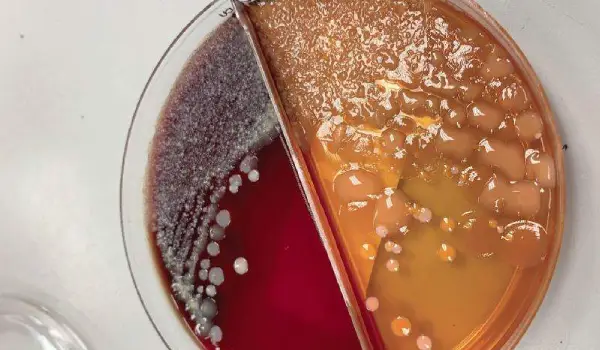

در تشخیص و درمان عفونتهای پوستی و بافتی، رعایت دقیق دستورالعمل نمونهگیری کشت زخم از اهمیت بالایی برخوردار است. انجام صحیح نمونه گیری از ترشحات زخم باعث میشود تا نوع میکروب، قارچ یا باکتری عامل عفونت را بهطور دقیق شناسایی گردد. البته نمونهگیری از ترشحات زخم یا انجام کشت خون با رعایت اصول بهداشتی و تجهیزات استریل انجام شود تا نتیجه کشت بهدرستی بیانگر وضعیت واقعی بافت آلوده باشد.
انجام آزمایشهای نمونهبرداری از عفونت و آزمایش کشت ترشحات واژن نیز در موارد خاص برای شناسایی عفونتهای باکتریایی و قارچی مورد استفاده قرار میگیرد. شناخت و تفسیر صحیح علائم مثبت شدن کشت خون مانند تب مداوم، لرز، افت فشار یا تغییر سطح هوشیاری، میتواند در تشخیص سریعتر عفونتهای سیستمیک حیاتی باشد.
در این مقاله، به بررسی علمی و عملی روشهای استاندارد کشت و نمونهبرداری از زخم، نکات کلیدی در جمعآوری نمونه، خطاهای رایج و تفسیر نتایج پرداخته میشود تا راهنمایی جامع برای متخصصان و دانشجویان علوم پزشکی فراهم گردد.
کشت زخم چیست و چه زمانی انجام میشود؟
کشت زخم (Wound Culture) یکی از آزمایشهای تخصصی در شاخهی میکروبیولوژی است که برای شناسایی نوع میکروب، باکتری یا قارچ موجود در زخمهای عفونی بهکار میرود. زمانی که زخم دچار ترشح، التهاب، قرمزی یا تاخیر در بهبود میشود، انجام این تست به پزشک کمک میکند تا علت دقیق عفونت مشخص شود. در بسیاری از موارد، ویزیت پزشک متخصص در منزل نیز میتواند با بررسی بالینی و تجویز کشت زخم، نوع میکروارگانیسم عامل بیماری را شناسایی کرده و بر اساس نتیجه، بهترین دارو یا آنتیبیوتیک را برای درمان مؤثر تجویز کند.
کشت زخم چه زمانی انجام میشود؟
کشت زخم علاوه بر کمک به تشخیص عامل عفونی، در تعیین حساسیت دارویی (Antibiotic Sensitivity Test) نیز نقش مهمی دارد. در نتیجه، انجام بهموقع کشت زخم یکی از دقیقترین روشها برای تشخیص و درمان مؤثر عفونت زخم محسوب میشود. دستورالعمل نمونه گیری کشت زخم معمولا در شرایط زیر و توسط پرستار خصوصی در منزل شیراز انجام میشود:
- وجود علائم واضح عفونت زخم مانند بوی نامطبوع، ترشحات چرکی یا درد مداوم
- عدم درمان و بهبود زخمها پس از چند روز
- بیماران دیابتی یا دارای نقص ایمنی
- زخمهای جراحی، سوختگی یا زخمهای فشاری (Pressure Ulcers)

مراحل نمونهبرداری از زخم
فرآیند نمونهبرداری برای کشت زخم از مهمترین مراحل تشخیص عفونتهای پوستی و زخمهای مزمن است. با انجام صحیح نمونه گیری از ترشحات زخم نتیجه کشت زخم دقیق و قابل اعتماد خواهد شد. مراحل آمادهسازی، برداشت نمونه و انتقال صحیح به آزمایشگاه عبارتند از:
- آمادهسازی بیمار و محیط کار:
پیش از شروع نمونهبرداری از زخم، برای کاهش آلودگی سطحی، ناحیه باید با محلول ضدعفونیکننده (مانند سرم نرمال سالین) تمیز شود و تمام ابزارها باید استریل و در محیطی تمیز آماده گردند. - انتخاب ناحیه مناسب برای نمونهگیری:
برای افزایش دقت در کشت زخم نمونه باید از قسمت فعال و تازه زخم گرفته شود. - برداشت زخم نمونه با ابزار مناسب:
بسته به نوع زخم، از سواب استریل (Swab)، سرنگ برای آسپیراسیون (Aspiration) یا نمونهبرداری با بافت (Tissue Biopsy) استفاده میشود. انتخاب روش بستگی به عمق زخم و شدت عفونت دارد. - قرار دادن نمونه در محیط انتقال (Transport Medium):
بلافاصله پس از برداشت زخم، نمونه باید در لوله یا محیط مخصوص حمل (Transport Medium) قرار گیرد تا از خشک شدن یا آلودگی جلوگیری شود. - برچسبگذاری و ثبت اطلاعات بیمار:
نام، نوع زخم، زمان نمونهگیری و سایر مشخصات روی ظرف نمونه کشت زخم درج گردد تا در آزمایشگاه اشتباه رخ ندهد. - ارسال سریع نمونه به آزمایشگاه:
نمونه برداری از عفونت و زخم باید در کوتاهترین زمان ممکن به آزمایشگاه میکروبیولوژی ارسال شود تا دقت نتایج کشت زخم حفظ گردد.
“جهت اجاره تخت بیمارستانی در شیراز کلیک کنید”
روشهای انجام کشت زخم در آزمایشگاه
انتخاب صحیح روشهای انجام کشت زخم (Wound Culture) نقش تعیینکنندهای در تشخیص دقیق عامل عفونت دارد. پس از دستورالعمل نمونه گیری کشت زخم، نمونه گرفته شده در محیطهای کشت اختصاصی قرار میگیرد تا نوع باکتری، قارچ یا میکروارگانیسم مسبب عفونت شناسایی شود. هر روش کشت، بسته به شرایط زخم و نوع عفونت، میتواند نتایج متفاوتی ایجاد کند که در انتخاب درمان و آنتیبیوتیک مناسب بسیار موثر است.
کشت زخم هوازی(Aerobic Culture)
کشت زخم هوازی، نمونهی زخم در محیطهایی با اکسیژن کافی قرار میگیرد تا میکروارگانیسمهای هوازی رشد کنند. این روش معمولا برای شناسایی باکتریهای سطحی و عفونتهای باز کاربرد دارد. پس از رشد کلنیها، بررسی مورفولوژی، رنگآمیزی گرم و آزمایش حساسیت دارویی انجام خواهد شد تا نوع دقیق باکتری و آنتیبیوتیک مؤثر مشخص شود.
کشت زخم بیهوازی (Anaerobic Culture)
در کشت بیهوازی، نمونه گیری از ترشحات زخم در محیطی عاری از اکسیژن نگهداری و کشت داده میشود. این روش برای تشخیص باکتریهای زخمهای عمقی، نکروتیک یا دارای ترشحات بدبو بهکار میرود که در شرایط بدون اکسیژن رشد میکنند. دمای ثابت، شرایط مرطوب و استفاده از محیطهای مخصوص بیهوازی از مهم ترین شرایط کشت زخم بی هوازی است.
محیطها و روشهای پیشرفته برای تشخیص عفونت زخم
برای افزایش دقت در کشت زخم، از محیطهای اختصاصی مانند Blood Agar، MacConkey Agar و Mannitol Salt Agar استفاده میشود تا بتوان رشد باکتریهای خاص را شناسایی کرد. در برخی آزمایشگاهها، از روشهای مولکولی پیشرفته مانند MALDI-TOF و تستهای سریع میکروبی برای تعیین نوع میکروب و حساسیت آنتیبیوتیکی بهره گرفته میشود. با این مرحله پزشک میتواند درمان هدفمند و موثری برای بیمار انتخاب کند.
تفاوت روشهای پیشرفته برای تشخیص عفونت زخم
| محیط کشت | نوع باکتری هدف | نوع محیط | نحوه تشخیص بین باکتریها |
|---|---|---|---|
| Blood Agar | گرم مثبت و منفی | عمومی (Enriched) | بررسی نوع همولیز |
| MacConkey Agar | گرم منفی | اختصاصی و افتراقی | تشخیص تخمیر لاکتوز |
| Mannitol Salt Agar | گرم مثبت (استافیلوکوکها) | اختصاصی و افتراقی | تشخیص تخمیر مانیتول |
تفسیر نتایج کشت زخم
پس از انجام کشت زخم و رشد میکروبها در محیطهای آزمایشگاهی، باید تفسیر نتایج کشت زخم انجام میشود. تفسیر نتایج کشت زخم از مراحل حساس این فرایند است، چون پزشک متخصص در منزل شیراز با بررسی ظاهر کلنیها، نوع باکتری و نتیجهی آنتیبیوگرام میکروب عامل عفونت زخم را مشخص میکند. گاهی همراه با کشت زخم، پزشک کشت خون را هم برای بررسی عفونت تجویز میکند. نتایج این بررسیها به انتخاب دقیقتر آنتیبیوتیک و پیشگیری از گسترش عفونت کمک خواهد کرد.
نتیجه منفی کشت زخم
در صورت عدم وجود میکروب در نتیجه کشت زخم نتیجه کشت منفی میشود. این نتیجه نشان میدهد که زخم عفونی نیست یا نمونهگیری بهدرستی انجام نشده است. البته در برخی موارد، شاید عامل عفونت غیرقابل رشد در محیط آزمایشگاهی باشد، بنابراین همیشه باید نتیجه با علائم بالینی بیمار مقایسه شود.
کشت زخم با نتیجه مثبت
با مشاهده رشد باکتری یا قارچ در محیط کشت، نتیجهی کشت زخم مثبت است. بنابراین، آزمایشگاه نوع میکروارگانیسم را مشخص کرده و آزمایش آنتیبیوگرام (Antibiotic Sensitivity Test) را برای مشخص کردن حساسیت دارویی انجام میدهد. در نتیجه علاوه بر درمان با بهترین انتی بیوتیک، از مصرف بیمورد داروها جلوگیری خواهد شد.
به طور کلی نتایج کشت زخم باید همراه با علائم بالینی، وضعیت عمومی بیمار و سابقهی درمان قبلی بررسی شوند. وجود ترشحات چرکی، بوی نامطبوع، درد، تورم یا تب مداوم از نشانههای عفونت فعال است. در این موارد، در صورت مثبت بودن کشت درمان ضدمیکروبی اختصاصی آغاز میشود. در بیماران با نتیجهی منفی ولی علائم ماندگار، ممکن است پزشک تصمیم به تکرار نمونهگیری یا بررسی روشهای دیگر مانند کشت بیهوازی یا PCR بگیرد.
“برای دریافت دستگاه زردی نوزاد در منزل شیراز، کلیک کنید.”
مراقبتهای قبل و بعد از نمونهبرداری زخم
رعایت نکات بهداشتی قبل و بعد از نمونهبرداری از زخم و آزمایش کشت ترشحات واژن،، نقش مهمی در دقت نتیجهی کشت زخم دارد. آمادهسازی مناسب پوست، استفاده از وسایل استریل و تمیز نگهداشتن محل زخم، احتمال آلودگی نمونه را کاهش میدهد. .
مراقبتهای قبل از نمونهبرداری از زخم
- تمیزی و خشک بودن ناحیه زخم پیش از کشت زخم
- پرهیز از استفادهی پماد، کرم یا آنتیبیوتیک موضعی ۲۴ ساعت قبل از نمونهگیری
- اطلاع پزشک از مصرف داروهای خوراکی یا تزریقی
- آمادهسازی ابزار و محیط کاملاً استریل
- اجتناب از پانسمان فشرده یا بسته قبل از مراجعه
- آرامش و همکاری بیمار هنگام انجام نمونهگیری از زخم و وصل سرم و تزریقات
مراقبتهای بعد از نمونهبرداری از زخم
- پوشش محل نمونهگیری با گاز یا پانسمان استریل
- حفظ تمیزی و خشکی ناحیه زخم تا چند ساعت پس از کشت زخم
- تعویض روزانه پانسمان با رعایت اصول بهداشتی
- جلوگیری از تماس زخم با آب یا مواد ضدعفونیکنندهی قوی
- مشاهده علائم هشداردهنده مانند قرمزی، تورم یا ترشح غیرعادی
- مراجعه به پزشک در صورت بروز درد یا تغییر در رنگ زخم
- پیگیری نتیجهی آزمایش و تفسیر توسط پزشک معالج
در پایان
در تشخیص و درمان عفونتها، انجام درست دستورالعمل نمونهگیری کشت زخم و کشت خون اهمیت حیاتی دارد. رعایت اصول بهداشتی در نمونهگیری از ترشحات زخم و آزمایش کشت ترشحات واژن، اجرای دقیق مراحل نمونهبرداری از عفونت، دقت نتایج را بهطور چشمگیری افزایش میدهد. آگاهی از علائم مثبت شدن کشت خون مانند تب، لرز یا ضعف عمومی، به درمان سریعتر و پیشگیری از عفونت کمک میکند
اگر بهدنبال دریافت بهترین خدمات پزشکی در سریعترین زمان هستید، مرکز شیراز درمان با همکاری پزشکان متخصص، خدماتی چون نمونهگیری در منزل، انجام کشت زخم و کشت خون، تفسیر نتایج آزمایشگاهی و پیگیری درمان را با بالاترین دقت و سرعت ارائه میدهد.
در منزل، انجام کشت زخم و کشت خون، تفسیر نتایج آزمایشگاهی و پیگیری درمان را با بالاترین دقت و سرعت ارائه میدهد.
سوالات متداول
تفاوت کشت ترشحات زخم با کشت بافتی چیست؟
در کشت ترشحات زخم، نمونه از سطح زخم یا ترشحات چرکی برای شناسایی میکروبهای سطحی جمعآوری میشود. اما در کشت بافتی (Tissue Culture)، نمونه از لایههای عمقیتر برداشته میشود تا عامل اصلی عفونت زخم مشخص گردد. همچنین کشت بافتی به علت دقت بیشتری در زخمهای مزمن یا مقاوم به درمان انجام میگیرد.
چه مدت طول میکشد تا جواب کشت زخم آماده شود؟
زمان آماده شدن نتیجهی کشت زخم معمولا بین ۴۸ تا ۷۲ ساعت است. در صورت نیاز به کشت بیهوازی یا انجام آنتیبیوگرام (Antibiotic Sensitivity Test)، ممکن است این زمان تا ۵ روز نیز افزایش یابد.
علائم مثبت شدن کشت خون چیست؟
علائم مثبت شدن کشت خون شامل تب، لرز، افت فشار خون، افزایش ضربان قلب و احساس ضعف عمومی است. در این حالت، کشت خون نشان میدهد که میکروب وارد جریان خون شده و نیاز به درمان سریع و تخصصی دارد





















